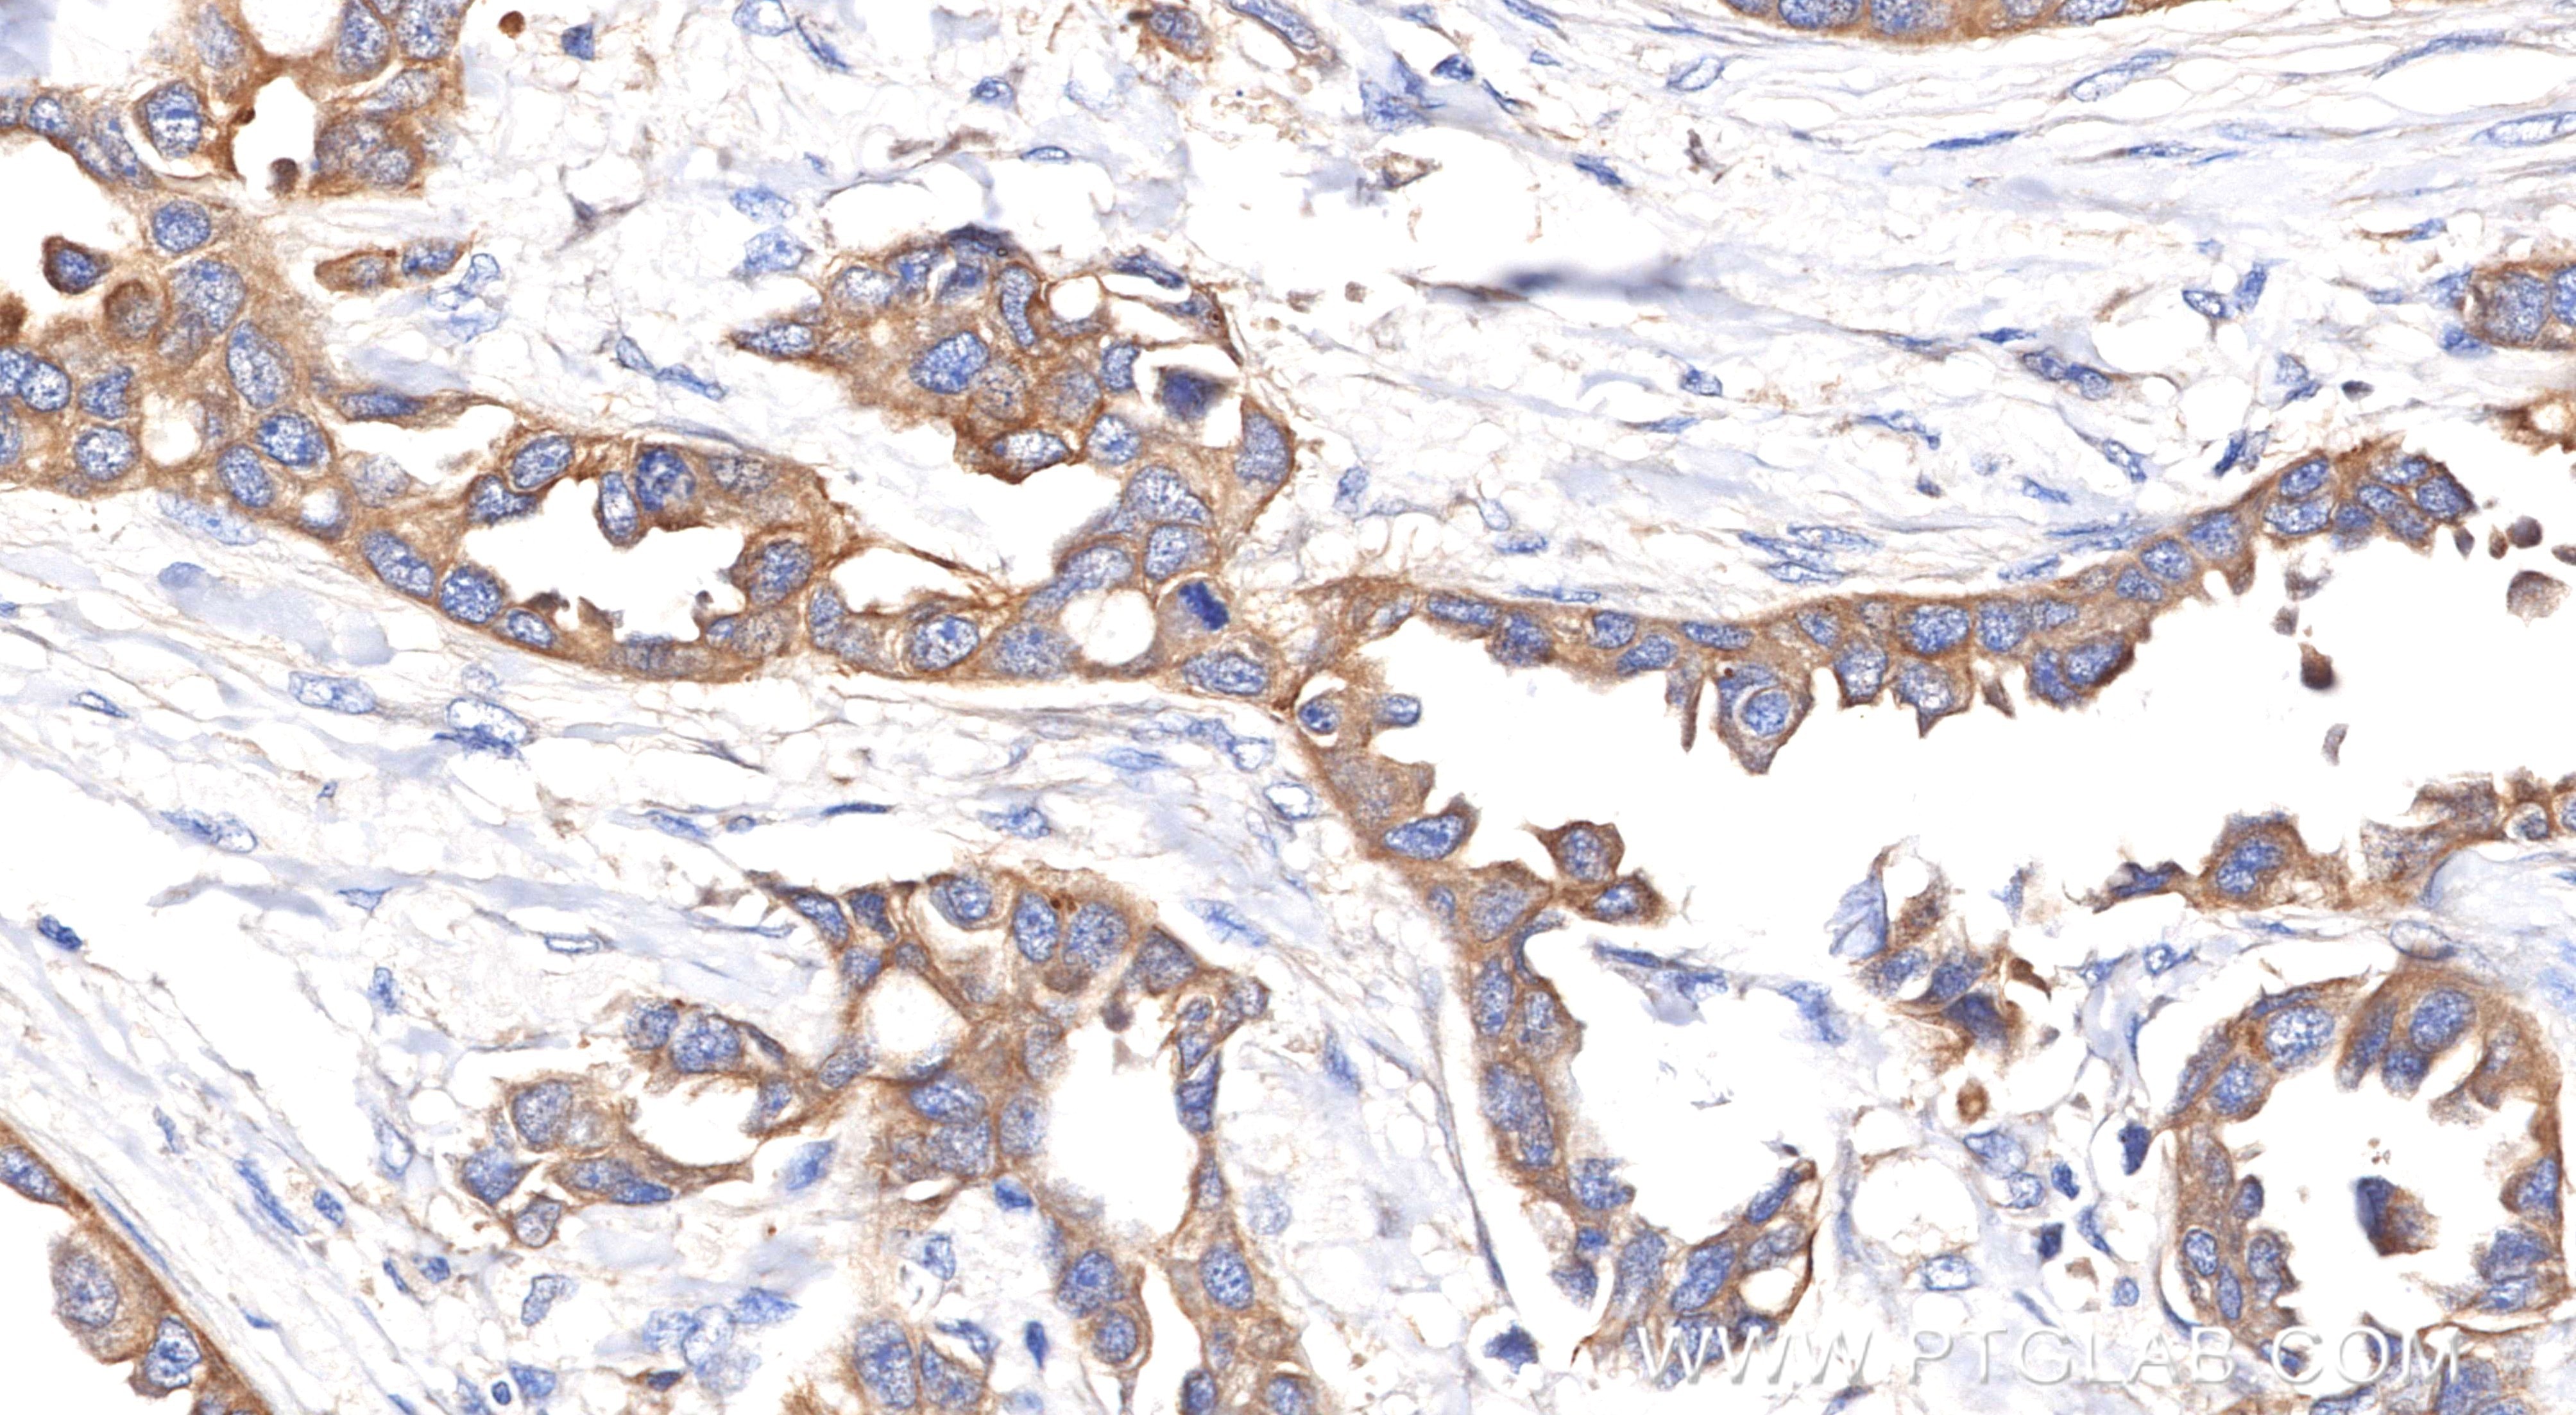
Immunohistochemical analysis of paraffin-embedded Human Breast Cancer(Her2+;ER-;PR-) slide using 86370-1-RR (Pan-Keratin (TypeⅡ) antibody) at dilution of 1:1000 (under 40x lens). Heat mediated antigen retrieval with Tris-EDTA buffer (pH 9.0). Immunohistochemistry (IHC) staining of Human Breast Cancer(Her2+;ER-;PR-) using Pan-Keratin (TypeⅡ) Recombinant monoclonal antibod (86370-1-RR)
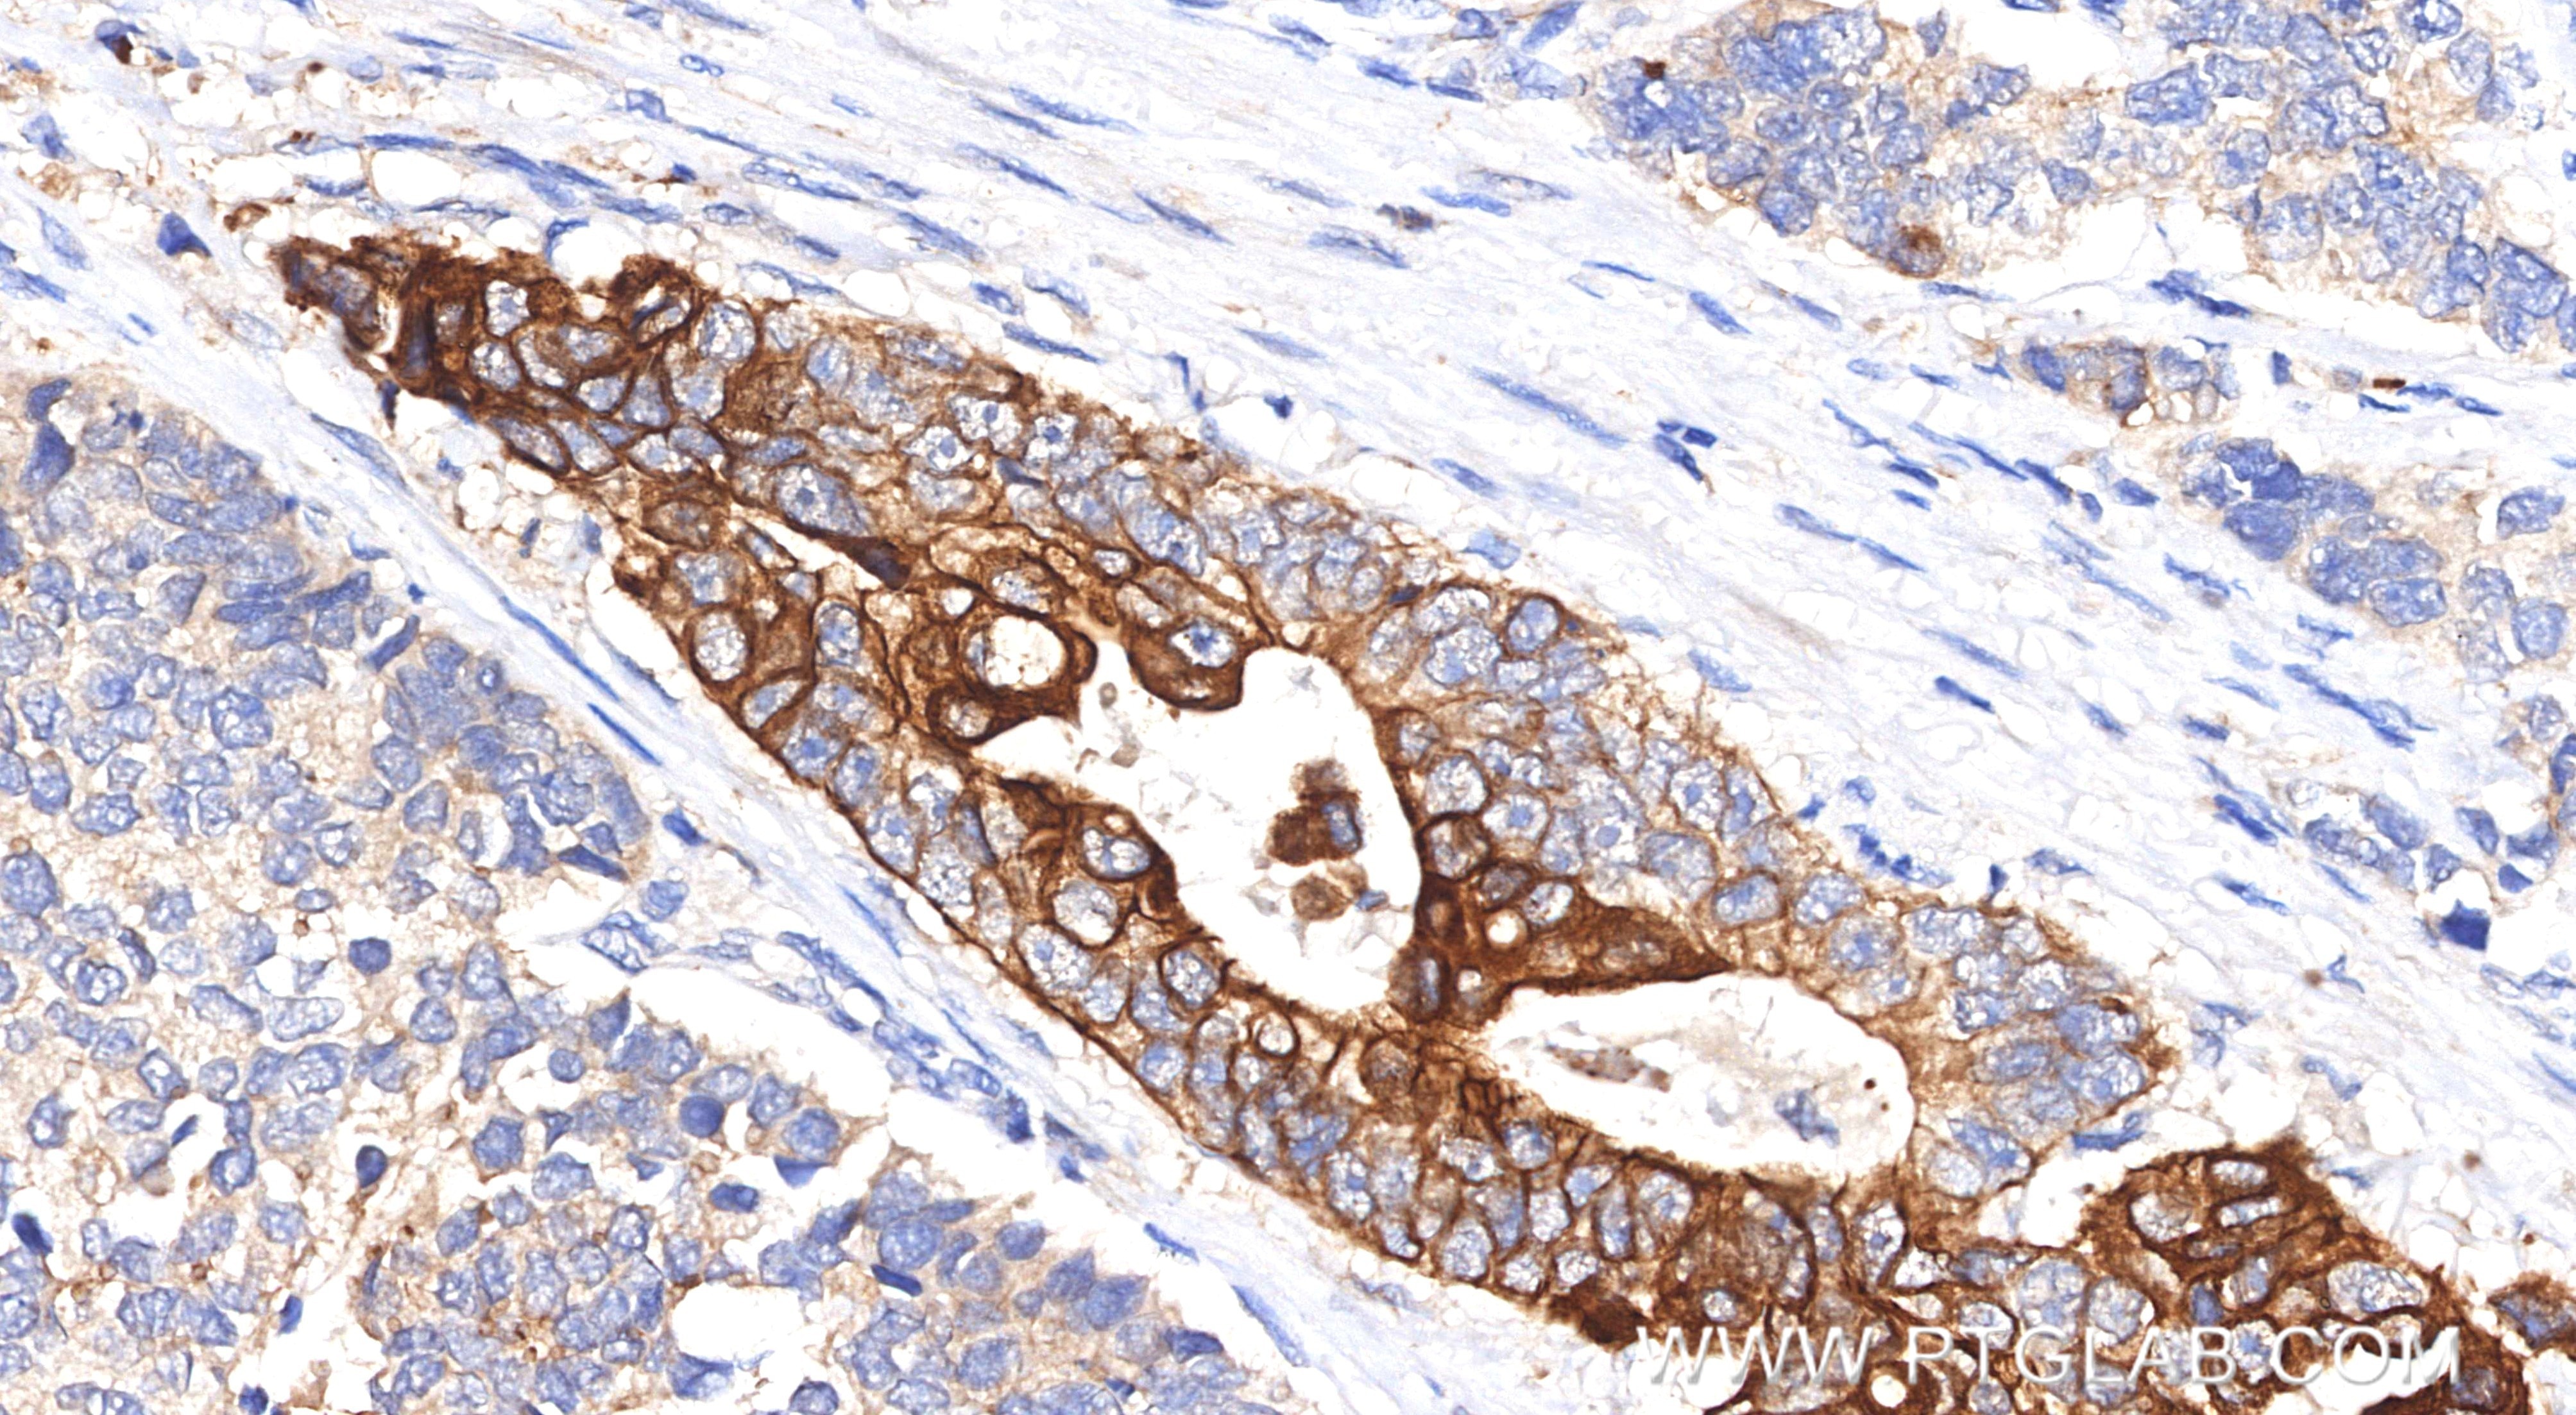
Immunohistochemical analysis of paraffin-embedded human stomach cancer tissue slide using 86370-1-RR (Pan-Keratin (TypeⅡ) antibody) at dilution of 1:1000 (under 40x lens). Heat mediated antigen retrieval with Tris-EDTA buffer (pH 9.0). Immunohistochemistry (IHC) staining of human stomach cancer tissue using Pan-Keratin (TypeⅡ) Recombinant monoclonal antibod (86370-1-RR)

Tested Applications
| Positive WB detected in | HeLa cells, A431 cells, HT-29 cells, mouse skin tissue, rat colon tissue, rat skin tissue |
| Positive IHC detected in | human stomach cancer tissue, Human Breast Cancer(Her2+;ER-;PR-) Note: suggested antigen retrieval with TE buffer pH 9.0; (*) Alternatively, antigen retrieval may be performed with citrate buffer pH 6.0 |
| Positive IF-P detected in | human colon cancer tissue, human cervical cancer tissue, human lung cancer tissue, mouse colon tissue, mouse skin tissue |
Recommended dilution
| Application | Dilution |
|---|---|
| Western Blot (WB) | WB : 1:5000-1:50000 |
| Immunohistochemistry (IHC) | IHC : 1:500-1:2000 |
| Immunofluorescence (IF)-P | IF-P : 1:250-1:1000 |
| It is recommended that this reagent should be titrated in each testing system to obtain optimal results. | |
| Sample-dependent, Check data in validation data gallery. | |
Product Information
86370-1-RR targets Pan-Keratin (TypeⅡ) in WB, IHC, IF-P, ELISA applications and shows reactivity with human, mouse, rat samples.
| Tested Reactivity | human, mouse, rat |
| Host / Isotype | Rabbit / IgG |
| Class | Recombinant |
| Type | Antibody |
| Immunogen |
Peptide Predict reactive species |
| Full Name | Pan-Keratin (TypeⅡ) |
| Observed Molecular Weight | 52-68 kDa |
| Gene Symbol | |
| Gene ID (NCBI) | Pan-Keratin (TypeⅡ) |
| Conjugate | Unconjugated |
| Form | Liquid |
| Purification Method | Protein A purification |
| UNIPROT ID | Q14533 |
| Storage Buffer | PBS with 0.02% sodium azide and 50% glycerol, pH 7.3. |
| Storage Conditions | Store at -20°C. Stable for one year after shipment. Aliquoting is unnecessary for -20oC storage. 20ul sizes contain 0.1% BSA. |
Background Information
Keratin is a family of fibrous structural proteins that are key components in hair, nails, feathers, hooves, and the outer layer of skin (epidermis). There are two main types of keratin: Type I (acidic) and Type II (basic/neutral), which form heterodimers to create intermediate filaments, providing mechanical strength to cells. Type II keratins (or Type II cytokeratins) are basic or neutral proteins that form part of the intermediate filament cytoskeleton in epithelial cells. Type II keratins include K1-K8, and K71-K86.
Protocols
| Product Specific Protocols | |
|---|---|
| IF protocol for Pan-Keratin (TypeⅡ) antibody 86370-1-RR | Download protocol |
| IHC protocol for Pan-Keratin (TypeⅡ) antibody 86370-1-RR | Download protocol |
| WB protocol for Pan-Keratin (TypeⅡ) antibody 86370-1-RR | Download protocol |
| Standard Protocols | |
|---|---|
| Click here to view our Standard Protocols |